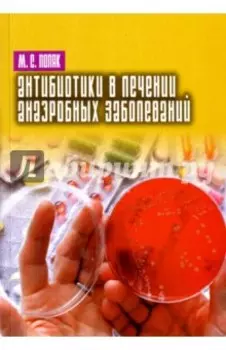
Антибиотики в лечении анаэробных заболеваний

-
 Нестор-История310 ₽
Нестор-История310 ₽Донна Анно | Вашему вниманию предлагается книга О. Марж "Донна Анно". None. Категория: Книги/Художественная литература/Современная проза/Современная отечественная проза
-
 Нестор-История264 ₽
Нестор-История264 ₽Самостоятельный байесовский подход | Дан байесовский подход в математической статистике, который поставляет не зависимые от параметра решения. Этим становится решенной проблема байесовского подхода к ...
-
 Нестор-История890 ₽
Нестор-История890 ₽Европейская культура. XXI век | В монографии осуществлен междисциплинарный анализ реалий европейской культуры в XXI веке. Авторы исследования утверждают, что последняя становится принципиально иной по...
-
 Нестор-История1280 ₽
Нестор-История1280 ₽Создатели современного эволюционного синтеза. Коллективная монография | Коллективная монография "Создатели современного эволюционного синтеза" посвящена историко-сравнительному анализу различных попыт...
-
 Нестор-История224 ₽
Нестор-История224 ₽Три различных сказа | Представляем вашему вниманию книгу "Три различных сказа". None. Категория: Книги/Художественная литература/Современная проза/Современная отечественная проза
-
 Нестор-История326 ₽
Нестор-История326 ₽Откуда и куда струится снежная река? | Иван Озаров (настоящая фамилия - Борисов) - писатель и компьютерщик в одном лице, живет в Москве, творит в жанре реалистической прозы, в которой совмещаются фило...
-
 Нестор-История1163 ₽
Нестор-История1163 ₽Как стать искусствоведом | Издание ставит перед собой высокие, но реальные цели нескучного обучения и небанального просвещения. Мир современного искусства раскроется перед вами в десяти тематических р...
-
 Нестор-История175 ₽
Нестор-История175 ₽Для Павловского и Прохорова раковая опухоль - пустяк | В свойственной ему юмористической манере автор рассказывает о табакокурении и его последствиях. Излагая свой опыт "дружбы с сигаретами", автор хо...
-
![Лазерный экологический дистанционный контроль атмосферы. Учебное пособие]() Нестор-История930 ₽
Нестор-История930 ₽Лазерный экологический дистанционный контроль атмосферы. Учебное пособие | В пособии основное внимание уделяется таким эффективным лазерным методам дистанционного зондирования атмосферы, как метод ком...
-
![Уверь]() Нестор-История930 ₽
Нестор-История930 ₽Уверь | О природе и людях, живших здесь раньше, и приезжих, полюбивших эти края, пойдёт разговор в предлагаемой читателю книге. None. Категория: Книги/Художественная литература/Современная проза/Совре...
-
![Автор в художественном тексте. Лингвистический аспект. "Маленькие" поэмы Сергея Есенина]() Нестор-История1395 ₽
Нестор-История1395 ₽Автор в художественном тексте. Лингвистический аспект. "Маленькие" поэмы Сергея Есенина | Автор художественного текста - глобальная и многоаспектная филологическая категория, эффективность изучения ко...
-
![Русские о Сербии и сербах. Том III. Сербские сочинения П.А. Ровинского]() Нестор-История1628 ₽
Нестор-История1628 ₽Русские о Сербии и сербах. Том III. Сербские сочинения П.А. Ровинского | В третий том серии публикаций источников «Русские о Сербии и сербах» вошли очерки и статьи о Сербии 1860-х — 1880-х гг. русског...
-
![Достоевский. Материалы и исследования. Т. 22]() Нестор-История1395 ₽
Нестор-История1395 ₽Достоевский. Материалы и исследования. Т. 22 | Очередной 22-й сборник периодического научного издания «Достоевский. Материалы и исследования» охватывает широкий круг вопросов, связанных с историей соз...
-
![Терракотовая пластика древнейших государств Средней Азии IV в. до н. э. - IV в. н. э.]() Нестор-История3932 ₽
Нестор-История3932 ₽Терракотовая пластика древнейших государств Средней Азии IV в. до н. э. - IV в. н. э. | Терракотовая пластика - одно из наиболее ярких явлений в материальной культуре древних историко-культурных облас...
-
![Антибиотики в лечении анаэробных заболеваний]() Нестор-История465 ₽
Нестор-История465 ₽Антибиотики в лечении анаэробных заболеваний | Антибиотикотерапия является важным компонентом комплекса лечебных мероприятий при заболеваниях, вызванных облигатно анаэробными бактериями (родов Bactero...
-
![Слово о полку Игореве. Путеводитель]() Нестор-История890 ₽
Нестор-История890 ₽Слово о полку Игореве. Путеводитель | Книга посвящена "Слову о полку Игореве" - одному из самых знаменитых и загадочных памятников русской литературы. В древнерусской словесности оно во многих отношен...
-
![Что такое Апокалипсис?Любовь!Любовь!]() Нестор-История147 ₽
Нестор-История147 ₽Что такое Апокалипсис?Любовь!Любовь! | Книга Скинии - Богчеловой Что такое Апокалипсис? Любовь! Любовь! None. Категория: Книги/Художественная литература/Современная проза/Современная отечественная про...
-
![Белый шарик. Повести]() Нестор-История698 ₽
Нестор-История698 ₽Белый шарик. Повести | Талантливая проза о нелёгкой, но богатой впечатлениями жизни автора в горбачёвском СССР, России и США. Прекрасный литературный язык, увлекательный сюжет, прекрасно подмеченные д...
-
![Небесный и земной Космос русской литературы конца XIX - начала XX века. Знаки и смыслы. Монография]() Нестор-История890 ₽
Нестор-История890 ₽Небесный и земной Космос русской литературы конца XIX - начала XX века. Знаки и смыслы. Монография | В монографии рассматривается феномен русской художественной философии как целостной содержательной ...
-
![Взгляд в античность. Varia]() Нестор-История1395 ₽
Нестор-История1395 ₽Взгляд в античность. Varia | Сборник статей профессора Гринбаума объединяет исследования, посвященные изучению языка античной литературы во всем разнообразии ее жанров. Книга рассчитана на широкий кру...
-
![Частная нива]() Нестор-История264 ₽
Нестор-История264 ₽Частная нива | Юмористические рассказы о быте современной деревни. None. Категория: Книги/Художественная литература/Современная проза/Современная отечественная проза
-
![D. S.M. / Д. П. Святополк-Мирский. Годы эмиграции, 1920 - 1932]() Нестор-История1068 ₽
Нестор-История1068 ₽D. S.M. / Д. П. Святополк-Мирский. Годы эмиграции, 1920 - 1932 | Книга посвящена деятельности выдающегося историка литературы и литературного критика кн. Д. П. Святополк-Мирского (1890-1939) в период ...
-
![В 3D]() Нестор-История698 ₽
Нестор-История698 ₽В 3D | Книга Евгении Бейкер "в 3D". None. Категория: Книги/Художественная литература/Современная проза/Современная отечественная проза
-
![Жизнь. Люди. Эпоха]() Нестор-История977 ₽
Нестор-История977 ₽Жизнь. Люди. Эпоха | В воспоминаниях, охватывающих период с 1924 по 1948 гг., А. З. Ваксер - доктор исторических наук профессор, лауреат Государственной премии СССР, научный сотрудник Санкт-Петербургс...
-
![Неназидательные заметки]() Нестор-История350 ₽
Нестор-История350 ₽Неназидательные заметки | Эта книга, так или иначе, о том, что тяга к путешествиям, к смене обстановки, к новым впечатлениям заставляет иногда бросить всё на время и ехать, чтобы оказаться в доселе не...
-
![Casus Владимира Печерина]() Нестор-История1068 ₽
Нестор-История1068 ₽Casus Владимира Печерина | Настоящая публикация представляет собой прямое продолжение подготовленного мной издания "В. С. Печерин. Apologia pro vita mea. Жизнь и приключения русского католика, рассказ...
-
![Ребята, которые любят думать]() Нестор-История264 ₽
Нестор-История264 ₽Ребята, которые любят думать | Предлагаем вашему вниманию книгу Риммы Цветковской "Ребята, которые любят думать". None. Категория: Книги/Книги для детей/Детская художественная литература/Проза для дет...
-
![Дневники и письма Николая Ивановича Тургенева. Том IV. Путешествие в Западную Европу. 1824-1825]() Нестор-История2668 ₽
Нестор-История2668 ₽Дневники и письма Николая Ивановича Тургенева. Том IV. Путешествие в Западную Европу. 1824-1825 | Дневник путешествия по немецким, австрийским и итальянским землям в 1824-1825 гг. видного русского пол...
-
![Языки мира. Языки манде]() Нестор-История2093 ₽
Нестор-История2093 ₽Языки мира. Языки манде | Книга является очередным томом многотомного энциклопедического издания "Языки мира", которое создается в Институте языкознания РАН. Данный том содержит описание языков семьи ...
-
![Андрей Платонов и литературная Москва]() Нестор-История1779 ₽
Нестор-История1779 ₽Андрей Платонов и литературная Москва | Взаимоотношения А. П. Платонова с его писательским окружением рассматриваются в контексте литературной жизни Москвы 1920-1940-х гг. Выясняется, почему Платонов ...
-
![Избранное: Статьи, переводы, комментарии]() Нестор-История979 ₽
Нестор-История979 ₽Избранное: Статьи, переводы, комментарии | В книгу избранных статей, переводов и комментариев вошли работы, посвященные изучению "Слова о полку Игореве", жизни и творчества А. С. Пушкина и поэмы А. А....
-
![У оврага... за последними домами]() Нестор-История582 ₽
Нестор-История582 ₽У оврага... за последними домами | Первый за последние два десятилетия двуязычный сборник авторов-туркменистанцев разных поколений, разных жизненных позиций и литературных стилей, как известных, так и...
-
![Комплект гирь для весов правосудия]() Нестор-История465 ₽
Нестор-История465 ₽Комплект гирь для весов правосудия | Книга "Комплект гирь для весов правосудия" - не детектив. Несмотря на то, что повесть, давшая название книге, посвящена повседневной работе следователя по расследо...
-
![Высокое и низкое в художественной культуре. Том 2]() Нестор-История629 ₽
Нестор-История629 ₽Высокое и низкое в художественной культуре. Том 2 | В 20 и начале 21 века привычные культурные иерархии неоднократно рушились. Категории высокого и низкого пересматривались, даже отменялись, но и дока...
-
![Пятьсот лет спустя, или 95 тезисов о Реформации]() Нестор-История698 ₽
Нестор-История698 ₽Пятьсот лет спустя, или 95 тезисов о Реформации | Пять столетий тому назад вместе с европейской Реформацией началась историческая эпоха, которую сегодня обозначают словом модерность. Христианская, про...
-
![Опыты]() Нестор-История310 ₽
Нестор-История310 ₽Опыты | Предлагаемая книга - первое художественное произведение автора. Она является своеобразной автобиографией, написанной в виде серии коротких занимательных рассказов. None. Категория: Книги/Худож...
-
![От "естественной религии" детства до старости]() Нестор-История534 ₽
Нестор-История534 ₽От "естественной религии" детства до старости | Книга Кивлевой Натальи Васильевны От "естественной религии" детства до старости. Сборник литературных набросков. None. Категория: Книги/Нехудожественная...
Учебники по литературе Нестор-история
В категории "учебники по литературе нестор-история" найдено товаров: 101 | Страница 2
Цена: